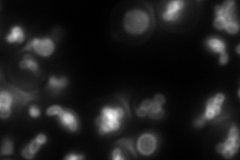
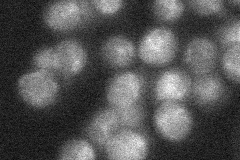
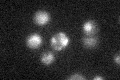

View description
Repressible alkaline phosphatase, a glycoprotein localized to the vacuole; regulated by levels of inorganic phosphate and by a system consisting of Pho4p, Pho9p, Pho80p, Pho81p and Pho85p; dephosphorylates phosphotyrosyl peptides
Localization:
Intensity:
Fold change:
Significance:
-
C’ GFP library in SD

below threshold16.86 -
N' NOP1pr-GFP in SD

vacuole membrane120.998 -
N' TEF2pr-mCherry in SD
vacuole membrane160.97 -
N' NATIVEpr-GFP in SD
below threshold22.8913 -
N' TEF2pr-VC and Cyto-VN in SD

vacuole membrane50.5574 -
C’ GFP library in SD+DTT

cytosol17.061.01No -
C’ GFP library in SD+H2O2

cytosol16.570.98No -
C’ GFP library in Starvation Media
vacuole27.141.6No -
C’ GFP library on the background of Pup2-DaMP

N/A -
C’ GFP library on the background of CCT mutant

N/A0N/AYes
